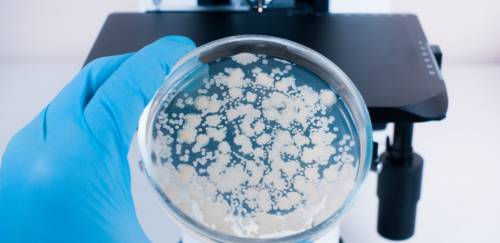
Saiba mais sobre as principais análises laboratoriais em pescado

MAPA propõe flexibilização para inovação em aditivos e coadjuvantes
Lex Experts (Sarah de Oliveira e Gustavo Faria) - 14 de outubro de 2025


Toxicidade do arsênio depende crucialmente de sua forma química
Jairo Gund - 31 de julho de 2025
Márcia Cioffi, gerente do Laboratório TUV SUD SFDK explica sobre as principais análises e processos
12 de julho de 2021
Especialista em marketing destaca que a categoria deve se apropriar do que já lhe pertence: saúde
23 de março de 2021
Pesquisa da Kantar aponta busca por mais saudabilidade
22 de janeiro de 2021